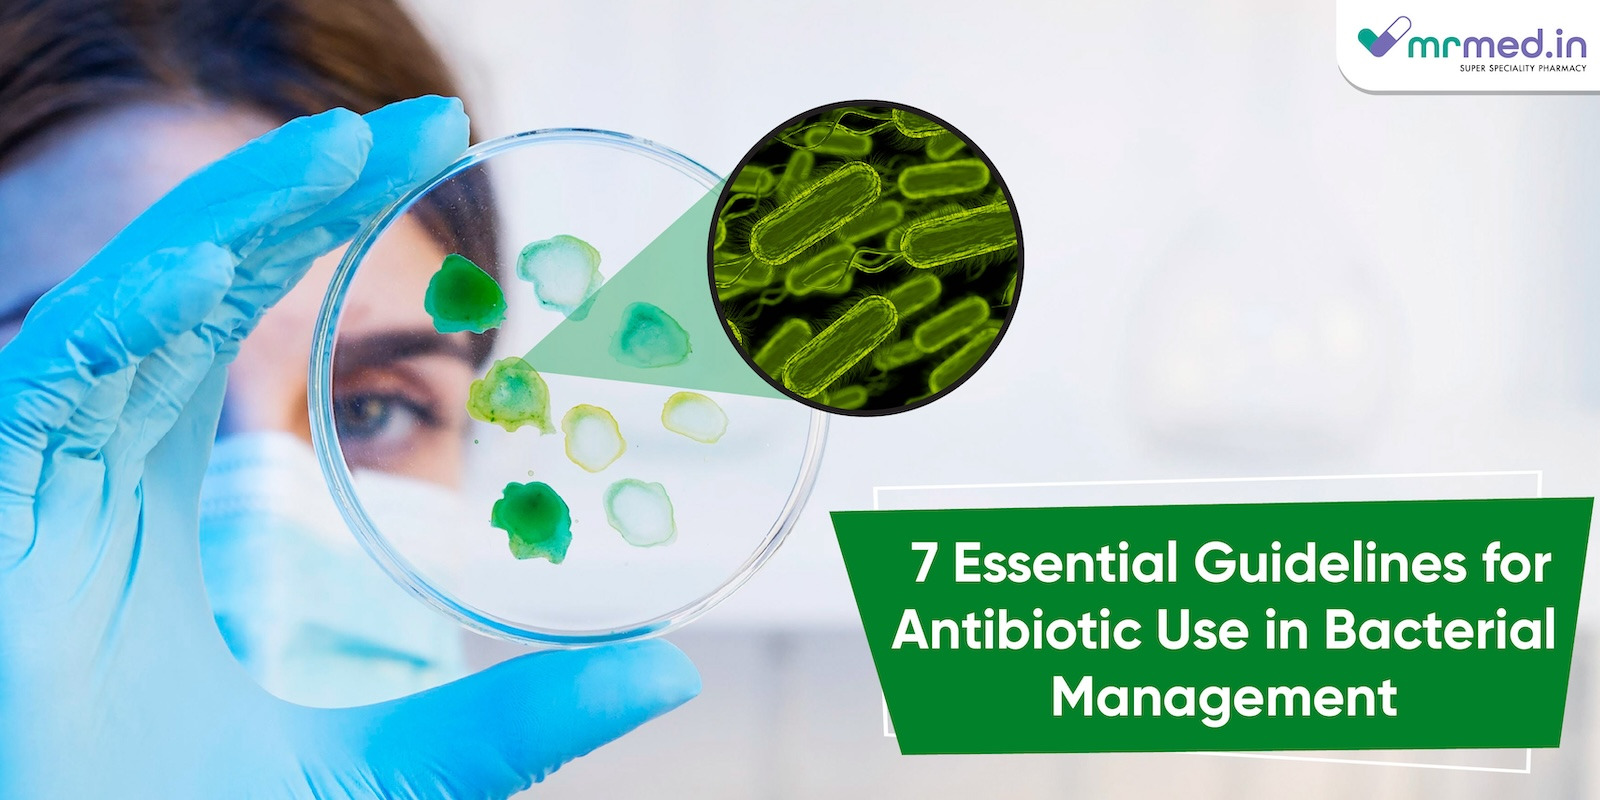

Bacteria are small microorganisms that have a tendency to create harmful infections in the human body. But only a few types of bacteria are involved in infections and can even pose a life-threatening risk to individuals. Fortunately, antibiotics exist to protect and treat us from harmful bacteria and their infections. However, before using antibiotics, it's important to understand how to choose the right one for our health to recover. Today, you can find guidance for choosing the right antibacterial medicine in this article.
What is a bacterial infection?
Bacterial infection can be transmitted through air, water, food, or living vectors to humans. It can cause mild to moderate symptoms in patients based on the type of bacteria that leads to infection. Bacterial infection can affect different parts of the human body, such as the throat, lungs, skin, bowel, urethra, or genital areas.
Common symptoms of bacterial infection
Some of the symptoms of bacterial infection are given below:
- Fever: Patients may have a rise in body temperature due to the body's immune response against the infection.
- Chills: Patients may experience a cold or shivering, which occurs at the beginning of infection.
- Pain or discomfort: Patients may experience body pain or discomfort in the throat, joints, ears, or urethra.
- Skin swelling or redness: Individuals may have swelling or redness in the infection site of their skin.
- Persistent cough: The patient may experience a persistent cough due to a respiratory infection.
- Shortness of breath: Patients may experience breathing difficulty or shortness of breath due to a respiratory infection.
- Fatigue: Individuals may experience tiredness or weakness during the bacterial infection.
- Headache: Patients may have lightheadedness or head pain due to the fever.
How do antibiotics work in treating bacterial infections?
Antibiotics are a type of medicine that helps in treating and preventing bacterial infection by killing or preventing the spread of bacteria in the body. They can be used as tablets, capsules, suspensions, creams, lotions, sprays, or drops.
What are the classifications of antibiotics based on the spectrum?
There various classifications are available to classify the antibiotic. But based on the spectrum activity of antibiotics (range of microbes it kills or target), they can be classified into three types, which are given below:
- Broad-spectrum antibiotics: They can treat a wide range antibiotics which include both gram positive and gram negative bacteria. Ampicillin, Piperacillin & Tazobactam (Tazact 4.5gm Injection), Chloramphenicol,Vancomycin and ofloxacin are some of the examples of broad spectrum antibiotics.
- Narrow-spectrum antibiotics: Narrow-spectrum antibiotics can treat only a certain range of bacteria. e.g. Penicillin G.
- Extended-spectrum antibiotics: They can cover a range of gram-negative bacteria in the treatment. e.g. Beta-lactam.
Seven Key Facts About Antibiotics
Here are the seven key facts about antibiotic which you need to know:
- Antibiotics can save people: Antibiotics are an effective tool in treating bacterial infections when they are used properly.
- Antibiotics are the only solution: If you have a cough or cold, you may not always need antibiotics to treat it. Sometimes, your immune system is more than enough to overcome such issues.
- Antibiotics do not treat a viral infection: You may have health issues that viruses can cause. Then, there is no point in using antibiotics to treat viral infections.
- Not all bacterial infections need antibiotics: If you have sinus or ear infections, they will resolve without using any antibiotics. However, it is crucial to consult your doctor if the symptoms get worse.
- Antibiotics won't make you better if you have a viral infection: People who have a respiratory viral infection may not respond to antibacterial medication. Speak with your doctor if you are not getting well even after a week.
- Use prescribed antibiotics only: It is crucial to follow the doctors prescribed medicine and stick on to prescribed dosage while using antibiotics. Overusing or unnecessary using of antibiotics will lead to a more complex condition known as antibiotic resistance.
- Antibiotics can treat life-threatening conditions: They can be helpful in treating severe life-threatening conditions like sepsis and certain types of pneumonia in patients.
Summing up!
Antibiotics are an essential tool in treating and improving the health of individuals. However, it is crucial to ensure that the doctor prescribes the antibiotics we use for our health to avoid complications like antibiotic resistance in our lives. It is recommended to speak with your doctor before using an antibiotic for an infection or health issue.